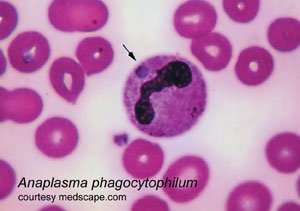

Лейкоциты у хаски: Когда стоит бить тревогу?
Наверное, каждый владелец хаски хотя бы раз сталкивался с вопросами здоровья своего питомца. И одним из показателей, вызывающих беспокойство, является уровень лейкоцитов в крови. Что это значит, когда он повышен, и что делать в такой ситуации? Давайте разберемся вместе, основываясь на нашем опыте и знаниях.
Что такое лейкоциты и зачем они нужны хаски?
Лейкоциты, или белые кровяные клетки, – это ключевые игроки иммунной системы. Они защищают организм от инфекций, вирусов, бактерий и других чужеродных агентов. Уровень лейкоцитов в крови – важный показатель здоровья, и его отклонения от нормы могут сигнализировать о различных проблемах.
У хаски, как и у других собак, нормальный уровень лейкоцитов находится в определенном диапазоне. Когда этот уровень повышается (лейкоцитоз), это может указывать на то, что организм борется с какой-то инфекцией или воспалением. Важно понимать, что повышение лейкоцитов – это не сама болезнь, а лишь симптом.
Причины повышения лейкоцитов у хаски
Причин повышения лейкоцитов может быть множество. Вот некоторые из наиболее распространенных:
- Инфекции: Бактериальные, вирусные или грибковые инфекции – одна из самых частых причин лейкоцитоза.
- Воспалительные процессы: Воспаление в любом органе может вызвать повышение уровня лейкоцитов.
- Травмы: После травм и операций организм также может реагировать повышением лейкоцитов.
- Стресс: Сильный стресс также может влиять на уровень лейкоцитов.
- Некоторые лекарства: Некоторые лекарственные препараты могут вызывать лейкоцитоз как побочный эффект.
- Онкологические заболевания: В некоторых случаях повышение лейкоцитов может быть связано с онкологическими заболеваниями.
Симптомы, сопровождающие повышенные лейкоциты
Важно понимать, что повышение лейкоцитов само по себе не имеет специфических симптомов. Симптомы будут зависеть от основной причины, вызвавшей лейкоцитоз. Среди наиболее распространенных симптомов, которые могут сопровождать повышенные лейкоциты, можно выделить:
- Лихорадка
- Слабость и вялость
- Потеря аппетита
- Кашель или чихание
- Диарея или рвота
- Изменения в поведении
Если мы замечаем у своего хаски какие-либо из этих симптомов, особенно в сочетании с вялостью и потерей аппетита, необходимо как можно скорее обратиться к ветеринару. Своевременная диагностика и лечение помогут предотвратить развитие серьезных осложнений.
Диагностика лейкоцитоза у хаски
Диагностика лейкоцитоза начинается с общего анализа крови. Он покажет не только уровень лейкоцитов, но и соотношение различных типов лейкоцитов (лейкоцитарная формула). Это может помочь определить, с каким типом инфекции или воспаления борется организм.
В зависимости от результатов общего анализа крови, ветеринар может назначить дополнительные исследования, такие как:
- Биохимический анализ крови
- Анализ мочи
- Рентген или УЗИ
- Анализ кала
- Цитологическое исследование (например, пункция лимфоузла)
Все эти исследования помогут выявить основную причину лейкоцитоза и назначить адекватное лечение.
«Здоровье – это еще не все, но все остальное без здоровья – ничто.»
⎯ Артур Шопенгауэр
Лечение повышенных лейкоцитов у хаски
Лечение лейкоцитоза направлено на устранение основной причины, вызвавшей повышение уровня лейкоцитов. Это может включать:
- Антибиотики: При бактериальных инфекциях.
- Противовирусные препараты: При вирусных инфекциях.
- Противогрибковые препараты: При грибковых инфекциях.
- Противовоспалительные препараты: Для снятия воспаления.
- Обезболивающие препараты: Для облегчения боли.
- Хирургическое вмешательство: В некоторых случаях может потребоваться хирургическое вмешательство, например, для удаления абсцесса или опухоли.
Важно строго следовать рекомендациям ветеринара и не заниматься самолечением. Неправильное лечение может привести к ухудшению состояния питомца.
Профилактика повышения лейкоцитов у хаски
Профилактика – лучший способ избежать проблем со здоровьем у хаски. Вот несколько простых советов, которые помогут поддерживать иммунитет вашего питомца в хорошем состоянии:
- Регулярные осмотры у ветеринара: Посещайте ветеринара не реже одного раза в год для профилактического осмотра и вакцинации.
- Сбалансированное питание: Обеспечьте своего хаски качественным кормом, богатым витаминами и минералами.
- Регулярные физические нагрузки: Хаски – активная порода, нуждающаяся в регулярных физических нагрузках.
- Гигиена: Следите за чистотой шерсти и ушей вашего питомца.
- Своевременная обработка от паразитов: Регулярно обрабатывайте хаски от блох, клещей и глистов.
- Избегайте стрессовых ситуаций: Постарайтесь избегать ситуаций, которые могут вызвать стресс у вашего питомца.
Наш опыт и советы
Помните, что здоровье вашего хаски – в ваших руках. Будьте внимательны к своему питомцу, и он отплатит вам любовью и преданностью!
Подробнее
| LSI Запрос 1 | LSI Запрос 2 | LSI Запрос 3 | LSI Запрос 4 | LSI Запрос 5 |
|---|---|---|---|---|
| Норма лейкоцитов у хаски | Симптомы инфекции у собак | Воспаление у хаски | Анализ крови у собак | Как укрепить иммунитет хаски |
| Диета для хаски с лейкоцитозом | Лечение лейкоцитоза у собак | Стресс и лейкоциты у собак | Признаки болезни у хаски | Ветеринарная помощь для хаски |